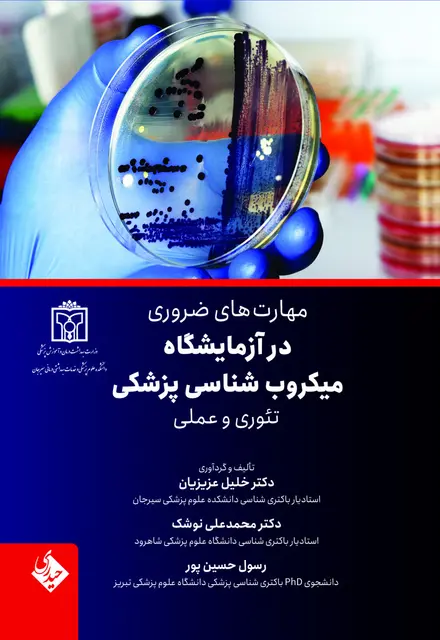
مهارت های ضروری در آزمایشگاه میکروب شناسی پزشکی تئوری و عملی - تصویر 1

مهارت های ضروری در آزمایشگاه میکروب شناسی پزشکی تئوری و عملی
زبان
فارسی
قطع
وزیری
نوع جلد
شومیز
تعداد صفحه
132
ردهبندی سنی
۱8+ (بزرگسال)
نوع چاپ
سیاهوسفید
سال چاپ
1401
نوبت چاپ
اول
وزن
250 گرم
ارسال سریع
ارسال ۲ ساعته به تهران و در اسرع وقت به شهرهای دیگر
قیمت:
۴۰۰٬۰۰۰ تومان
1
بدون امتیاز
هنوز امتیازی ثبت نشده
برای ثبت نظر و امتیازدهی وارد حساب کاربری خود شوید
ورود / ثبت نام💬
هنوز نظری ثبت نشده است
اولین نفری باشید که نظر میدهید!
.png)






































.png)
.png)

.png)